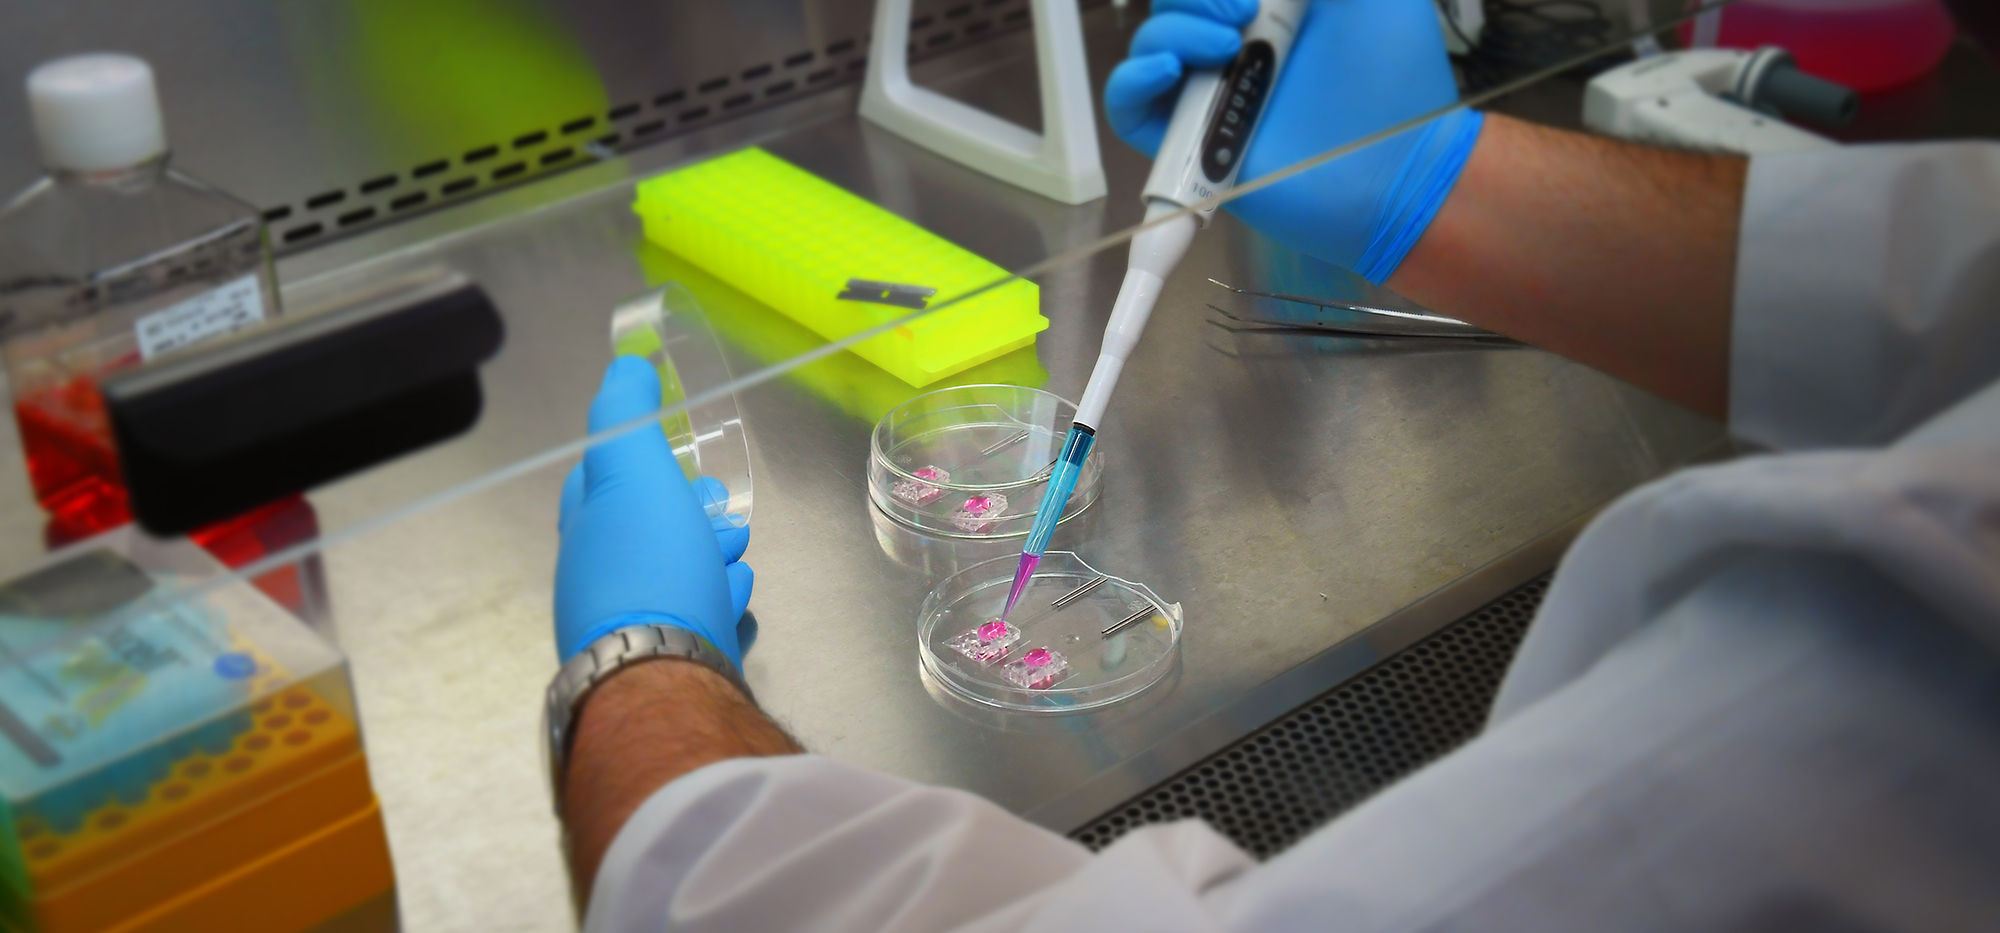
#

Contact Us
We have done our best to put Financial Aid information at your fingertips, however, we know we may have missed something! We are happy to answer any additional questions you may have.
Rowan University complies with the Family Educational Rights & Privacy Act (FERPA). Our colleagues cannot discuss account details with anyone except the student without their written consent. Students who wish to give permission for a third-party to access their account must submit a FERPA Waiver to the Registrar's Office.
Identity Verification Steps:
- In-person: Duo Mobile push, or verification of biographical information, or review of a Rowan University ID and/or government-issued photo ID
- Telephone: Duo Mobile push or confirmation of biographical information
- Email: Must be sent from your Rowan University email address
International Students: Before making an appointment with our office to discuss financial aid options, please be sure you have reached out to the Rowan International Center and are in the process of submitting the required documentation for admissions.
Christine L. Willse, MBA
Campus Director
Joelle Reyes
Associate Director
Student Financial Aid Office - Stratford Campus
113 East Laurel Road
PO Box 1011
Stratford, NJ, 08084